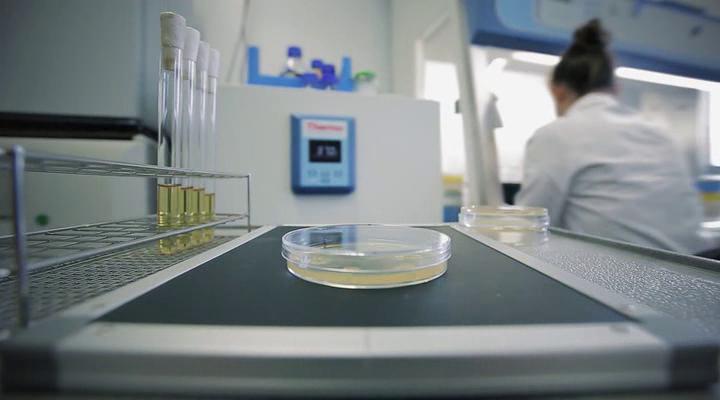
snapshot

Коронавирус. Все, что нужно знать
--
6.1
--
Сезоны:
0.0
Ваша оценка
51мин 12+2020ДокументальныйРоссия
Мы выясним, есть ли эффективная профилактика от заражения коронавирусом, почему маски не защищают, и какие способы заразиться, кроме прямого контакта с заболевшим, наиболее вероятны. Что такое современные вакцины от вирусов, как их производят, и почему вакцина от коронавируса – это дело не сегодняшнего дня. И почему, при всей заразности вируса, массовая вакцинация, скорее всего, не понадобится?
Языки:rus